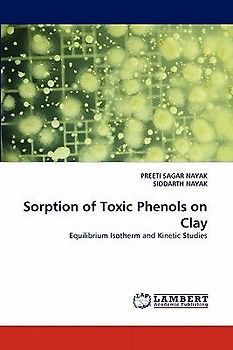
Sorption of Toxic Phenols on Clay

Techno-economic Analysis on Renewable Energy Hybrid Systems

State- and Property-Specific Quantum Chemistry and Physics II

On the temperature dependence on the stochastic dynamic mass spectrometric diffusion parameter

NOUVEAUX MATÉRIAUX D'ÉLECTRODES NEGATIVES POUR BATTERIES LITHIUM-ION

CHEMICAL KINETICS

Strategies in design of Alzheimer's disease drugs

Piridoxamina: cofactor enzimático e inhibidor de la glicación protéica

Mikrobereichsanalytik an marinen Biomineralisationsprodukten

Bestimmung von androgenen und antiandrogenen Substanzen in wässrigen Umweltproben mit biologischen und chemischen Methoden

Entwicklung einer Methode zur Analyse von Pestiziden in Nebelwasser durch Festphasen-Extraktion und Flüssigkeitschromatographie gekoppelt mit Electrospray-Tandem-Massenspektrometrie
Sorption of Toxic Phenols on Clay

Combustion nanoparticles from aviation and shipping

Alcohols Permeability in Nafion Membranes for Direct Alcohol Fuel Cell

Quantum theory of activated rate processes

HPLC-Methoden zur Analyse ausgewählter Carbamate. Entwicklung, Konzentrationsstabilität und Toxizität im akuten Daphnientest

The Young's Partition Method in Combinatorial Enumeration

Anleitung zur Analyse organischer Körper

De novo design of dual acting compounds for venous thromboembolism

Integrated Computational Approaches in Hydrolysis of Biomolecules

Spektroskopische Untersuchungen zur Effektivität und Dauerhaftigkeit von Hydrophobierungsmitteln auf der Basis von Organosiliciumverbindungen auf mineralischen Oberflächen

Agricultura, Ciencia y Conciencia

Elaboration de Nouveaux Matériaux d'Electrodes

Quantum modelling of some potent, non-toxic schiff base complexes

Vibrational spectra and DFT study of certain bioactive molecules

Integral Encounter Theory of Photochemical Transfer Reactions

Properties of Crystalline Materials by X-ray Diffraction Methods and Symmetry Groups
Lieber Geld verdienen als ausgeben?
Verkauf Elektronik und Medien ganz einfach an uns
Versand immer kostenlos und versichert 100 % Löschung deiner Daten Erfahrung und Sicherheit seit 2004
Der Streichpreis bezieht sich auf die unverbindliche Preisempfehlung des Herstellers, den aktuellen durchschnittlichen Neupreis des Produktes bei idealo Deutschland, oder bei Büchern auf den festgelegten Preis für Neuware.




